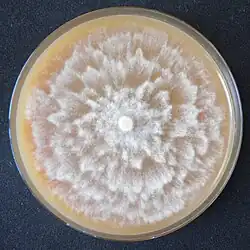
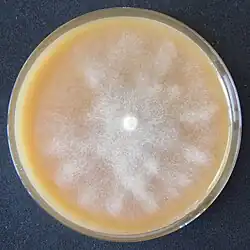

Česká sbírka fytopatogenních oomycetů

Česká sbírka fytopatogenních oomycetů (ČSFO) byla založena v roce 2005 na Odboru biologických rizik ve Výzkumném ústavu Silva Taroucy pro krajinu a okrasné zahradnictví, v.v.i. (nyní Výzkumný ústav pro krajinu, v. v. i.) v Průhonicích. Sbírka je od r. 2012 součástí Národního programu konzervace a využívání genetických zdrojů mikroorganismů a drobných živočichů hospodářského významu (NPGZM),[1] který je financován Ministerstvem zemědělství ČR a jehož cílem je zabezpečit trvalé uchování, dostupnost a setrvalé využívání genetických zdrojů významných pro výživu a zemědělství, které se nacházejí na území Česka.
Sbírka slouží především k uchování kmenů fytopatologicky významných druhů oomycetů náležejících do rodů Phytophthora de Bary 1876 a Pythium Pringsh. 1858 sensu lato, který je v současnosti rozdělen do rodů Elongisporangium Uzuhashi, Tojo & Kakish. 2010, Globisporangium Uzuhashi, Tojo & Kakish. 2010, Phytopythium Abad, De Cock, Bala, Robideau, A.M. Lodhi & Lévesque 2010 a Pythium Pringsh. 1858 sensu stricto. Ve veřejné části sbírky je uloženo přes 660 kmenů oomycetů náležejících do rodů Phytophthora (36 taxonů), Elongisporangium (4 taxony), Globisporangium (8 taxonů), Phytopythium (6 taxonů) a Pythium (6 taxonů). V pracovní části sbírky je uloženo přes 500 dalších kmenů.

Taxonomie
Doména: Eukaryota
Říše: Chromista
Oddělení: Oomycota
Třída: Oomycetes
Řády: Pythiales a Peronosporales

Význam fytopatogenních oomycetů
Fytopatogenní oomycety zejm. druhy r. Phytophthora, jsou jedny z nejvýznamnějších a nejcitovanějších patogenů rostlin, každoročně způsobují škody v řádu miliard dolarů. Tyto druhy se obvykle velmi snadno šíří (spolu s rostlinným materiálem a vodou), patří mezi nejvíce invazní a škodlivé organismy světa a v místech zavlečení mnohdy hrozí jejich únik do přírodního prostředí a případně i závažné environmentální škody.[2]
Typickými symptomy napadení oomycety jsou nejčastěji hniloby kořenů a krčků (fytoftorová kořenová hniloba), které se obvykle projevují vadnutím, žloutnutím a zmenšením listů, krněním a špatným vývinem a postupným chřadnutím a odumíráním napadených hostitelů a jejich porostů (fytoftorové odumírání). Mezi běžné projevy patří také např. nekrotizace napadených pletiv, padání klíčních rostlin. Některé druhy r. Phytophthora jsou schopny se šířit i vzduchem a mohou tak napadat i nadzemní orgány rostlin a způsobovat nekrotické léze na listech a výhonech.[3]


Zaměření a využití sbírky
Sbírka se soustřeďuje na uchování genetických zdrojů vybraných zástupců oomycetů z území Česka, zejména pak na aktuální hrozby – na druhy recentně pronikající na území Česka, které mají zároveň potenciál uniknout do volné přírody, a slouží jako podpora pro jejich další výzkum.
Mezi uchovávanými organismy je řada celosvětově nejvýznamnějších patogenů rostlin.[4] V ČSFO jsou uloženy kmeny např. takových druhů jako je plíseň olšová Phytophthora alni způsobující zásadní škody v porostech olšin a v břehových porostech,[5][6][7] plíseň skořicová P. cinnamomi patřící mezi nejvíce invazní organismy světa,[8] plíseň kaktusová P. cactorum polyfágní druh poškozující v Česku zejména ovocné dřeviny,[9][10] plíseň buková P. cambivora a druh P. plurivora, v Česku již široce rozšířené druhy pronikající i do lesních porostů,[11][12] P. ramorum [13][14] a mnohých dalších významných patogenů jakými jsou P. citrophthora, P. cryptogea, P. syringae atd.
Uložené kmeny jsou poskytovány celé řadě různých institucí k výzkumným, studijním, srovnávacím a dalším účelům. Do zahraničí jsou kmeny často poskytovány pro taxonomické studie a populační studie, na úrovni národní slouží k celé řadě výzkumů směřujících svými výsledky do praxe (např. testy citlivosti lesních a okrasných dřevin, testy rezistence podnoží ovocných dřevin, testy odolnosti vůči fungicidním přípravkům, vývoj metod integrované ochrany apod.).[15][16][17][18] Mezi spolupracující či výsledky využívající instituce patří např. MŽP, MZe, AOPK ČR, PřF UK, LČR, ÚHÚL, Povodí Vltavy, Povodí Labe, VŠUO Holovousy, Svaz školkařů ČR, Ovocnářská unie ČR a další.
Získávání a identifikace kmenů
Kmeny jsou získávány zejména v rámci výzkumné činnosti Odboru biologických rizik VÚKOZ[19] (např. projekty TH02030521,[20] SS02030018,[21] TH02030722)[22] a v kooperaci s dalšími institucemi. Uchovávaný materiál byl doposud získán z více než 100 různých taxonů hostitelů, patřících zejména mezi okrasné rostliny, ovocné a lesní dřeviny, z celé řady různých stanovišť od skleníkových provozů, zahradnictví a zahradnických center, přes prodejny, soukromé zahrady, veřejnou zeleň, školkařské provozy, sady až po břehové a lesní porosty.
Uložené kmeny jsou určovány na základě morfologických a kultivačních znaků (zpravidla pohlavních znaků, znaků na nepohlavních orgánech, růstových charakteristik apod.) a pomocí metod molekulární analýzy (sekvence ITS rDNA oblastí, COX1 genu, případně dalších). Velká část kmenů je zdokumentována také pomocí mikroskopických snímků a v mnoha případech je zdokumentováno i poškození, které konkrétní patogen na hostiteli způsobil. Patogenita vybraných kmenů je ověřována infekčními pokusy v rámci vědeckých prací, při kterých jsou konkrétní kmeny využity.[9][11][15][16]
Způsob uchovávání kmenů
Jednotlivé kmeny jsou uchovávány na šikmých agarech (ovesný agar) ve zkumavkách v chladnicích při teplotě 12 °C. Jejich stav je pravidelně kontrolován a jsou přeočkovávány v intervalu 2–3 let. Pro dlouhodobé uchovávání a zabezpečení sbírkových kmenů je paralelně využívána metoda kryoprezervace, kmeny jsou touto metodou postupně ukládány v centrální laboratoři NPGZM v Ruzyni.
Databáze informací
Dokumentace ke každému kmenu obsahuje následující informace: evidenční (přírůstkové) číslo kultury, latinské jméno (včetně autorské zkratky), lokalitu (s uvedením zeměpisných souřadnic), datum izolace, druhové latinské jméno hostitele (substrát), ze kterého byl kmen izolován včetně přesného určení napadených pletiv (typu choroby), údaj o posledním přeočkování kultury, podrobnější údaje týkající se molekulární identifikace, párovacího typu, kódu sekvence v GenBank,[23] zařazení v jiných sbírkách kultur, autora izolace či poskytovatele a autora morfologického určení. Údaje jsou uloženy v databázi sbírky kultur, která je vedena v programu Microsoft Access. Katalog kmenů uložených ve sbírce je dostupný na webových stránkách ČSFO.[24] Sbírka je také součástí databáze Centrálního informačního systému sbírek CARC v Praze-Ruzyni.[25]

Seznam uložených taxonů
Phytophthora alni subsp. alni C.M. Brasier & S.A. Kirk
Phytophthora alni subsp. uniformis C.M. Brasier & S.A. Kirk
Phytophthora bilorbang Aghighi & T.I. Burgess
Phytophthora cactorum (Lebert & Cohn) J. Schröt.
Phytophthora cambivora (Petri) Buisman
Phytophthora cinnamomi Rands
Phytophthora citrophthora (R.E. & E.H. Smith) Leonian
Phytophthora cryptogea Pethybridge & Lafferty
Phytophthora gallica T. Jung & J. Nechwatal
Phytophthora gonapodyides (H.E. Petersen) Buisman
Phytophthora gregata T. Jung, Stukely & T.I. Burgess
Phytophthora hedraiandra De Cock & Man in 't Veld
Phytophthora chlamydospora Brasier & E.M. Hansen
Phytophthora chlamydospora x amnicola [26]
Phytophthora inundata Brasier, Sánch. Hern. & S.A. Kirk
Phytophthora lacustris Brasier, Cacciola, Nechwatal, Jung & Bakonyi
Phytophthora megasperma Drechsler
Phytophthora multibullata Q.N. Dang & T.I. Burgess
Phytophthora multivora P.M. Scott & T. Jung
Phytophthora nicotianae Breda de Haan
Phytophthora niederhauseri Z.G. Abad & J.A. Abad
Phytophthora occultans Man in ’t Veld & Rosendahl
Phytophthora palmivora E. J. Butler
Phytophthora pini Leonian
Phytophthora plurivora T. Jung & T.I. Burgess
Phytophthora polonica Belbahri, E. Moralejo, Calmin & Oszako
Phytophthora pseudocryptogea Safaief., Mostowf., G.E. Hardy & T.I. Burgess
Phytophthora pseudosyringae T. Jung & Delatour
Phytophthora ramorum Werres, De Cock & Man in 't Veld
Phytophthora rosacearum (H.E. Petersen) Buisman
Phytophthora rubi (W.F. Wilcox & J.M. Duncan) Man in 't Veld
Phytophthora sansomeana E.M. Hansen & Reeser
Phytophthora syringae (Kleb.) Kleb.
Phytophthora taxon Raspberry [27]
Phytophthora taxon Walnut [27]
Phytophthora x stagnum [28]
Elongisporangium anandrum (Drechsler) Uzuhasi, Tojo & Kakish.
Elongisporangium dimorphum (F.F. Hendrix & W.A. Campb.) Uzuhasi, Tojo & Kakish.
Elongisporangium helicandrum (Drechsler) Uzuhasi, Tojo & Kakish.
Elongisporangium undulatum (H.E. Petersen) Uzuhasi, Tojo & Kakish.
Globisporangium cylindrosporum (B. Paul) Uzuhashi, Tojo & Kakish.
Globisporangium heterothallicum (W.A. Campb. & F.F. Hendrix) Uzuhashi, Tojo & Kakish.
Globisporangium intermedium (de Bary) Uzuhashi, Tojo & Kakish.
Globisporangium irregulare (Buisman) Uzuhashi, Tojo & Kakish.
Globisporangium macrosporum (Vaartaja & Plaäts-Nit.) Uzuhashi, Tojo & Kakish.
Globisporangium mamillatum (Meurs) Uzuhashi, Tojo & Kakish.
Globisporangium spiculum (B. Paul) Uzuhashi, Tojo & Kakish.
Globisporangium ultimum (Trow) Uzuhashi, Tojo & Kakish.
Phytopythium chamaehyphon (Sideris) Abad, de Cock, Bala, Robideau, Lodhi & Lévesque
Phytopythium citrinum (B. Paul) Abad, de Cock, Bala, Robideau, Lodhi & Lévesque
Phytopythium helicoides (Drechsler) Abad, de Cock, Bala, Robideau, Lodhi & Lévesque
Phytopythium litorale (Nechw.) Abad, de Cock, Bala, Robideau, Lodhi & Lévesque
Phytopythium mercuriale (Belbahri, B. Paul & Lefort) Abad, de Cock, Bala, Robideau, A.M. Lodhi & Lévesque
Phytopythium vexans (de Bary) Abad, de Cock, Bala, Robideau, Lodhi & Lévesque
Pythium conidiophorum Jokl
Pythium dissimile Vaartaja
Pythium emineosum Bala, de Cock & Lévesque
Pythium folliculosum B. Paul
Pythium oopapillum Bala & Lévesque
Pythium pachycaule Ali-Shtayeh
Reference
- ↑ https://old.vurv.cz/mikroorganismy/index.html
- ↑ ERWIN, D. C. Phytophthora diseases worldwide. St. Paul, Minn.: APS Press xii, 562 pages s. Dostupné online. ISBN 0-89054-212-0, ISBN 978-0-89054-212-5. OCLC 35393235
- ↑ MRÁZKOVÁ, Marcela; ČERNÝ, Karel; STRNADOVÁ, Veronika, et al. Identifikace symptomů napadení dřevin a okrasných rostlin patogeny z rodu Phytophthora de Bary.. 1. vyd. Průhonice: VÚKOZ, v.v.i., 2012. 37 s. Dostupné online. S. 1–37.
- ↑ EPPO Global Database. gd.eppo.int [online]. [cit. 2024-02-05]. Dostupné online.
- ↑ CERNY, K.; GREGOROVA, B.; STRNADOVA, V. Phytophthora alni causing decline of black and grey alders in the Czech Republic. Plant Pathology. 2008-04, roč. 57, čís. 2, s. 370–370. Dostupné online [cit. 2023-02-09]. ISSN 0032-0862. doi:10.1111/j.1365-3059.2007.01718.x. (anglicky)
- ↑ ČERNÝ, Karel; STRNADOVÁ, Veronika. Phytophthora alder decline: disease symptoms, causal agent and its distribution in the Czech Republic. Plant Protection Science. 2010-03-31, roč. 46, čís. 1, s. 12–18. Dostupné online [cit. 2023-02-09]. doi:10.17221/43/2009-PPS.
- ↑ MIZERIENE, Goda; CERNY, Karel; ZYKA, Vladimir. Patterns of Genetic Diversification in the Invasive Hybrid Plant Pathogen Phytophthora × alni and Its Parental Species P. uniformis. Phytopathology®. 2020-12, roč. 110, čís. 12, s. 1959–1969. Dostupné online [cit. 2023-02-09]. ISSN 0031-949X. doi:10.1094/PHYTO-12-19-0475-R. (anglicky)
- ↑ BURGESS, Treena I.; SCOTT, John K.; MCDOUGALL, Keith L. Current and projected global distribution of Phytophthora cinnamomi , one of the world's worst plant pathogens. Global Change Biology. 2017-04, roč. 23, čís. 4, s. 1661–1674. Dostupné online [cit. 2023-02-09]. ISSN 1354-1013. doi:10.1111/gcb.13492. (anglicky)
- ↑ a b GRÍGEL, Juraj; ČERNÝ, Karel; MRÁZKOVÁ, Marcela. Phytophthora root and collar rots in fruit orchards in the Czech Republic. Phytopathologia Mediterranea. 2019-09-23, roč. 58, čís. 2, s. 261–275. Dostupné online [cit. 2023-02-09]. doi:10.14601/Phytopathol_Mediter-10614.
- ↑ ČERNÝ, Karel. Integrovaná ochrana ovocných dřevin před patogeny z r. Phytophthora. [Průhonice]: [s.n.] 35 stran s. Dostupné online. ISBN 978-80-87674-35-2, ISBN 80-87674-35-9. OCLC 1260123155
- ↑ a b MRÁZKOVÁ, Marcela; ČERNÝ, Karel; TOMŠOVSKÝ, Michal. Occurrence of Phytophthora multivora and Phytophthora plurivora in the Czech Republic. Plant Protection Science. 2013-12-31, roč. 49, čís. 4, s. 155–164. Dostupné online [cit. 2023-02-09]. doi:10.17221/74/2012-PPS.
- ↑ ČERNÝ, Karel; TSYKUN, Tetyana; STRNADOVÁ, Veronika, et al. Plíseň buková – nebezpečný invazní patogen buku lesního zdomácněl v ČR. Ochrana přírody. 2020-08-30, roč. 2020, čís. 4, s. 26, 27. Dostupné online.
- ↑ GRÜNWALD, Niklaus J.; GOSS, Erica M.; IVORS, Kelly. Standardizing the Nomenclature for Clonal Lineages of the Sudden Oak Death Pathogen, Phytophthora ramorum. Phytopathology®. 2009-07, roč. 99, čís. 7, s. 792–795. Dostupné online [cit. 2023-02-09]. ISSN 0031-949X. doi:10.1094/PHYTO-99-7-0792. (anglicky)
- ↑ BRASIER, Clive; WEBBER, Joan. Sudden larch death. Nature. 2010-08, roč. 466, čís. 7308, s. 824–825. Dostupné online [cit. 2023-02-09]. ISSN 0028-0836. doi:10.1038/466824a. (anglicky)
- ↑ a b ČERNÝ, Karel. Integrovaná ochrana ovocných dřevin před patogeny z r. Phytophthora. [Průhonice]: [s.n.] 35 stran s. Dostupné online. ISBN 978-80-87674-35-2, ISBN 80-87674-35-9. OCLC 1260123155
- ↑ a b ČERNÝ, Karel. Integrovaná ochrana sazenic v lesních školkách před patogeny z r. Phytophthora. [Průhonice]: [s.n.] 35 stran s. Dostupné online. ISBN 978-80-87674-37-6, ISBN 80-87674-37-5. OCLC 1260124589
- ↑ LAŇAR, Luděk; ČERNÝ, Karel, et al. Metodika hodnocení citlivosti podnoží ovocných dřevin vůči patogenům z r. Phytophthora. 1. vyd. Holovousy: VÝZKUMNÝ A ŠLECHTITELSKÝ ÚSTAV OVOCNÁŘSKÝ HOLOVOUSY s.r.o., Výzkumný ústav pro krajinu a okrasné zahradnictví, v.v.i., 2020. 27 s. ISBN 978-80-87030-77-6, 978-80-87674-36-9. S. 1–27.
- ↑ BOŽIK, Matěj; MRÁZKOVÁ, Marcela; NOVOTNÁ, Karolína. MALDI-TOF MS as a method for rapid identification of Phytophthora de Bary, 1876. PeerJ. 2021-07-19, roč. 9, s. e11662. Dostupné online [cit. 2023-02-09]. ISSN 2167-8359. doi:10.7717/peerj.11662. PMID 34322319. (anglicky)
- ↑ Odbor biologických rizik [online]. [cit. 2024-02-05]. Dostupné online.
- ↑ Jednoduché vyhledávání - IS VaVaI. www.isvavai.cz [online]. [cit. 2024-02-05]. Dostupné online.
- ↑ Jednoduché vyhledávání - IS VaVaI. www.isvavai.cz [online]. [cit. 2024-02-05]. Dostupné online.
- ↑ Jednoduché vyhledávání - IS VaVaI. www.isvavai.cz [online]. [cit. 2024-02-05]. Dostupné online.
- ↑ GenBank Overview. www.ncbi.nlm.nih.gov [online]. [cit. 2024-02-05]. Dostupné online.
- ↑ Sbírka fytopatogenních oomycetů [online]. [cit. 2024-02-05]. Dostupné online.
- ↑ https://old.vurv.cz/collections/vurv.exe/search?lang=cz
- ↑ NAGEL, Jan H.; GRYZENHOUT, Marieka; SLIPPERS, Bernard. Characterization of Phytophthora hybrids from ITS clade 6 associated with riparian ecosystems in South Africa and Australia. Fungal Biology. 2013-05, roč. 117, čís. 5, s. 329–347. Dostupné online [cit. 2023-02-09]. doi:10.1016/j.funbio.2013.03.004. (anglicky)
- ↑ a b BRASIER, Clive M.; COOKE, David E.L.; DUNCAN, James M. Multiple new phenotypic taxa from trees and riparian ecosystems in Phytophthora gonapodyides-P. megasperma ITS Clade 6, which tend to be high-temperature tolerant and either inbreeding or sterile. Mycological Research. 2003-03, roč. 107, čís. 3, s. 277–290. Dostupné online [cit. 2023-02-09]. doi:10.1017/S095375620300738X. (anglicky)
- ↑ YANG, Xiao; RICHARDSON, Patricia A.; HONG, Chuanxue. Phytophthora ×stagnum nothosp. nov., a New Hybrid from Irrigation Reservoirs at Ornamental Plant Nurseries in Virginia. PLoS ONE. 2014-07-29, roč. 9, čís. 7, s. e103450. Dostupné online [cit. 2023-02-09]. ISSN 1932-6203. doi:10.1371/journal.pone.0103450. PMID 25072374. (anglicky)